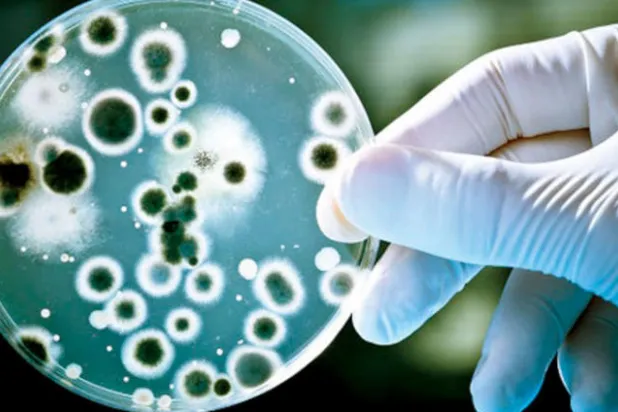
حفظ الأصول الأحيائية لإنقاذ العالم

Editor selections
اختيارات المحرر
يقول العلماء الأميركيون إننا سنكون في المستقبل، على موعد مع سائل زهري اللون غير سام، سيستخدم لتزويد المركبات الفضائية بالوقود ودفع السفن والمركبات الفضائية نحو القمر أو العوالم الأخرى.
يؤثر الإعلام أشد التأثير على العقول والأفكار والتوجهات وغيرها مما يؤدي إلى تغيير خصائص المجتمعات بما يطرح من أفكار، ويكون التأثير سلوكياً أو عاطفياً أو معرفياً، حيث يغير الإعلام قناعات الناس واهتماماتهم وقدواتهم وعلاقاتهم الاجتماعية، بالإضافة إلى التأثير في القرارات السياسية وغيرها. وظلت الصحافة تلعب هذا الدور، بمختلف أشكالها، ورقية كانت أو إلكترونية لكن الأمر الذي يعيد تشكيل التساؤلات منذ أكثر من 15 عاما خاصة في العالم العربي هو أن أمر زوال الورق يشكل هاجسا لدى أجيال الصحف والإعلام بشكل عام. واليوم، أعادت مواقع التواصل الاجتماعي في السعودية تاريخ الصحافة ونشأتها مؤكدة أنها باقية والتغير في قو
أعلن «الجيش الوطني» بقيادة المشير خليفة حفتر، مقتل «عشرين على الأقل من الميليشيات الموالية لحكومة الوفاق» التي يترأسها فائز السراج في معارك جديدة للسيطرة على مطار العاصمة طرابلس، تزامناً مع مناقشة قمة طارئة للاتحاد الأفريقي في النيجر ملف الأزمة الليبية. وأشار «المركز الإعلامي لغرفة عمليات الكرامة» التابع لـ«الجيش الوطني» في بيان أمس إلى «دحر هجوم للميليشيات على منطقة الأحياء البرية بطريق المطار الدولي المهجور للعاصمة طرابلس، وتدمير مدفعين 23 مضادين للطائرات، وعربات مسلحة برشاشات»، ولفت البيان إلى «مقتل نحو عشرين شخصا، بينما هرب باقي الفلول» على حد تعبيره. بدوره قال «اللواء 73 مشاة» التابع لـ«ا
قالت جماعات حقوقية ونشطاء يعملون في الإنقاذ يوم السبت إن ما لا يقل عن 544 مدنيا قتلوا وأصيب أكثر من 2000 منذ بدء هجوم بقيادة روسيا على آخر معقل للمعارضة المسلحة في شمال غربي سوريا قبل نحو شهرين. وانضمت الطائرات الروسية للجيش السوري في 26 من أبريل (نيسان) في أكبر هجوم على مناطق بمحافظة إدلب التي تسيطر عليها المعارضة وشمال محافظة حماة المتاخمة لها، في أكبر تصعيد في الحرب بين الرئيس السوري بشار الأسد ومعارضيه منذ الصيف الماضي. وقالت الشبكة السورية لحقوق الإنسان التي تتابع الخسائر وتقدم إفادات إلى وكالات تابعة للأمم المتحدة، إن 544 مدنيا قتلوا في مئات الهجمات نفذتها الطائرات الروسية والجيش السوري
اعتقل الجيش الإسرائيلي فلسطينياً بتهمة دهس مجموعة جنود إسرائيليين في الضفة الغربية ليلة السبت، ما أدى إلى إصابة 5، بينهم ثلاثة بحالة فوق المتوسطة. وصدمت سيارة فلسطينية الجنود بالقرب من حاجز حزما، شمال شرقي القدس، ثم لاذت بالفرار. وقال الجيش أمس إنه اعتقل السائق ووالده كذلك من بلدة حزما الفلسطينية. وأكد الجيش أنه «يتم التحقيق معهما». وقال الجيش في بيان أنه يعتبر الحادث «هجوماً إرهابياً». وجاء هذا التقييم بعدما قال الجيش في البداية إنه يحقق في طبيعة الحادث.
وصف السفير البريطاني لدى الولايات المتحدة الرئيس الأميركي دونالد ترمب وإدارته بأنّهما «ليسا على كفاءة»، وقال إن أداءهما «معطّل بشكلٍ غير مسبوق»، وفقاً لمذكرات دبلوماسية مسربة نشرتها أمس صحيفة «ذا ميل أون صنداي» البريطانية. ونُقل عن السّفير كيم داروش في مذكّرات سرّية أُرسلت إلى بريطانيا واطّلعت عليها الصحيفة، قوله إنّ رئاسة ترمب قد «تتحطّم وتحترق» و«تنتهي بوَصمة عار». وجاء في إحدى المذكّرات المزعومة المنسوبة إلى داروش: «لا نعتقد حقّاً أنّ هذه الإدارة ستُصبح طبيعية أكثر، وأقلّ اختلالاً، وأقلّ مزاجيّة، وأقلّ تشظّياً، وأقلّ طيشاً من الناحية الدبلوماسية (...)».
مع بدء المحادثات بين وفد من القادة السياسيين وشخصيات المجتمع الأفغاني وقيادات من حركة «طالبان» في الدوحة، لإنهاء 18 عاماً من الحرب، فجّرت «طالبان» شاحنة مفخخة في مقر الاستخبارات الأفغانية بمدينة غزني جنوب شرقي العاصمة كابل، مما أدى إلى مقتل اثني عشر شخصاً وجرح 177 آخرين حسب مصادر حكومية أفغانية. وأعلنت «طالبان» المسؤولية عن تفجير الشاحنة، حيث أعلن ذبيح الله مجاهد في بيان له: «سقط العشرات من أفراد مديرية الأمن الحكومية بين قتيل وجريح». وأكد عارف نوري الناطق باسم حاكم ولاية غزني مقتل ثمانية أفرد من مديرية الأمن وأربعة مدنيين آخرين وجرح أكثر من خمسين مدنياً.
رد اتحاد أميركا الجنوبية لكرة القدم «كونميبول» أمس الأحد، على التصريحات النارية التي أطلقها النجم الأرجنتيني ليونيل ميسي بعد طرده خلال المباراة التي فاز فيها التانجو على نظيره منتخب تشيلي بهدفين مقابل هدف في مباراة تحديد المركز الثالث لبطولة «كوبا أميركا». وذكر كونميبول في بيانه «في كرة القدم هناك رابح وخاسر، وإحدى الركائز الأساسية للعب النظيف، هي قبول النتائج باحترام وإخلاص، وينطبق الشيء نفسه على قرارات الحكام، والتي تصدر عن بشر ولن تصل أبدا لحد الكمال». وأضاف البيان «الاتهامات التي تم توجيهها تنم عن نقص الاحترام للبطولة ولجميع اللاعبين المشاركين، ومئات من المحترفين في اتحاد أميركا الجنوبية ا
يسعى المنتخب التونسي في مواجهته ضد غانا في الدور ثمن النهائي لبطولة كأس الأمم الأفريقية لكرة القدم المقامة في مصر، إلى تعويض الأداء المخيب الذي قدمه في دور المجموعات، وتفادي مصير الخروج المفاجئ للمغرب المرشح ومصر المضيفة، كما تلتقي مالي مع كوت ديفوار اليوم أيضاً في صدام ساخن من أجل مقعد بربع النهائي. في المباراة الأولى على ملعب الإسماعيلية سيكون المنتخب التونسي مطالباً بالارتقاء بمستواه إذا ما أراد مواصلة حلم إحراز اللقب القاري للمرة الثانية في تاريخه، بعد 2004 حين توج بطلاً على أرضه، لا سيما أن ما قدمه في دور المجموعات لن يكون كافياً لتخطي عقبة منتخب بحجم غانا التي وصلت إلى نصف النهائي على أق
طلبت مصر رسمياً من بريطانيا منع خروج تمثال للإله آمون على هيئة توت عنخ آمون، كانت دار «كريستيز» للمزادات قد باعته يوم 4 يوليو (تموز) الحالي، لحين اتخاذ القاهرة الإجراءات القانونية اللازمة لاستعادة التمثال.
تحدت أنواع من أزهار الزنبق المائي الظروف القاهرة، ونمت مجدداً في منطقة تشيرنوبل، التي تصنف على أنها منطقة غير قابلة للحياة، منذ أن تعرضت لكارثة نتيجة تسرب نووي من محطتها في أبريل (نيسان) عام 1986، ومنذ ذلك الحين يعتقد البعض عند سماع اسم «تشيرنوبل»، أن الطبيعة هناك ماتت نهائياً، وأن المنطقة مخيفة، مثل ما تعرضه أحياناً بعض الأفلام السينمائية.
في هذه اللحظة بالذات، تعيش مليارات الكائنات الحية المجهرية داخل أجسامنا وتؤثر في عمليات حيوية كثيرة، مثل التغذية والمناعة والنشاط الهرموني. وتشمل هذه الكائنات البكتيريا والفيروسات والفطريات، وهي تعرف باسم الأحياء الدقيقة، أو الميكروبات التي تنتشر ليس فقط في جسم الإنسان، بل في جميع الأوساط، كالتربة والهواء والماء.